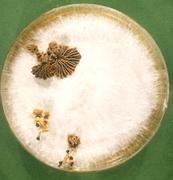
wallpaper-1689754

Rundholz mit Antenne
Aug. 2, 2010
Holzi

Mein Blog
Holz mit Know How, holzwurm-page
Die Artikel des Blogs Holz mit Know How, holzwurm-page wurden 223 mal geteilt